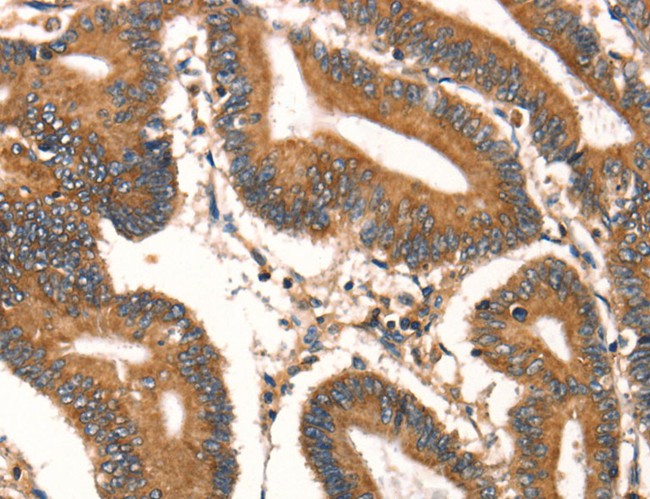
product-image-AAA169183_IHC13.jpg

Other Kit Components at 2 - 8 degree C
Application Data
(HL-60 cells were labeled with FAM-FLISPand ICT's SR-VAD-FMK FLICA caspasereagent (kit #917) after incubation withcamptothecin for 3 hours. Cells with activeserine proteases stain green (FAM-FLISP,y-axis, Fig. 1) and cells with active caspasesstain red (SR-VAD-FMK, x-axis, Fig. 5).Co-localization of serine protease activityversus caspase activity is evident in duallystained cells (Figs. 2, 3, 4, & 6).The DIC image(Fig. 7) reveals many negative cells (Dr.Zbigniew Darzynkiewicz, Brander CancerCenter).)
Background: Chymotrypsin-like enzymes cleave their substrate proteins at the carboxy terminus of amino acids containing hydrophobic aliphatic or aromatic R-group side chains such as those found on leucine and phenylalanine amino acid structures [1]. Compared to our FAM-F-DAP FLISP probe, the FAM-L-DAP FLISP probe contains a leucine amino acid rather than a phenylalanine in the P1 position. Because both leucine and phenylalanine contain a hydrophobic R-group side chain structure, they could both represent a type of fluorescent- labeled analog of the early chymotrypsin-like enzyme inhibitor N-tosyl- L-phenylalanine chloromethyl ketone (TPCK) [2]. Early studies using topoisomerase inhibitors in HL-60 cells indicated that TPCK, N-tosyl-L-lysine chloromethyl ketone (TLCK) and other serine protease inhibitors were able to prevent internucleosomal DNA degradation associated with apoptosis [3]. Dual staining experiments have used our original green FLISP chymotrypsin detection probe (FAM-F-CMK) and red FLICA poly caspase detection probe in the presence or absence of z-VAD-FMK, TPCK, or TLCK caspase or serine protease inhibitors with published success [2,4]. alpha-Aminoalkyl phosphonates were developed to address the need for reagents capable of covalently labeling the reactive serine-OH amino acid groups within the catalytic sites of serine proteases [5-6]. Chloromethyl ketone-based inhibitors very efficiently perform the task of labeling serine proteases but also have the capability of reacting with other enzymes and proteins in a non-specific manner and are more subject to hydrolysis over time in aqueous/cell culture media environments [7]. FLISP probes, containing this peptidyl ?-aminoalkylphosphonate (DAP) organophosphorus inhibitor structure, seek to satisfy the need for a reactive yet specific mechanism for labeling chymotrypsin-like serine proteases in whole living cells.
Customer Reviews
Loading reviews...
Share Your Experience
Similar Products
Product Notes
The FAM-Leu-DAP (Catalog #AAA52724) is an Assay Kit and is intended for research purposes only. The product is available for immediate purchase. It is sometimes possible for the material contained within the vial of "FAM-Leu-DAP Green FLISP, Assay Kit" to become dispersed throughout the inside of the vial, particularly around the seal of said vial, during shipment and storage. We always suggest centrifuging these vials to consolidate all of the liquid away from the lid and to the bottom of the vial prior to opening. Please be advised that certain products may require dry ice for shipping and that, if this is the case, an additional dry ice fee may also be required.Precautions
All products in the AAA Biotech catalog are strictly for research-use only, and are absolutely not suitable for use in any sort of medical, therapeutic, prophylactic, in-vivo, or diagnostic capacity. By purchasing a product from AAA Biotech, you are explicitly certifying that said products will be properly tested and used in line with industry standard. AAA Biotech and its authorized distribution partners reserve the right to refuse to fulfill any order if we have any indication that a purchaser may be intending to use a product outside of our accepted criteria.Disclaimer
Though we do strive to guarantee the information represented in this datasheet, AAA Biotech cannot be held responsible for any oversights or imprecisions. AAA Biotech reserves the right to adjust any aspect of this datasheet at any time and without notice. It is the responsibility of the customer to inform AAA Biotech of any product performance issues observed or experienced within 30 days of receipt of said product. To see additional details on this or any of our other policies, please see our Terms & Conditions page.Item has been added to Shopping Cart
If you are ready to order, navigate to Shopping Cart and get ready to checkout.